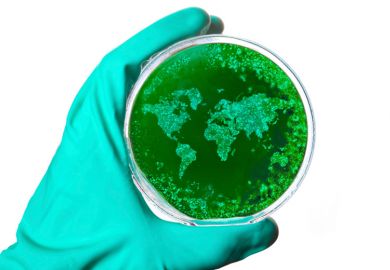

The Sharing Economy: The End of Employment and the Rise of Crowd-Based Capitalism
Arun Sundararajan
MIT Press
Here we go: blockchain, Uber, Airbnb, TaskRabbit, “microentrepreneur”, “disruptive”. Essential reading as much for what it leaves out (no index entries for “union”, “workplace safety”, “tax avoidance”, “free rider”, “job security” – or “sharecropping”) as for what the Stern School of Business scholar makes his techno-utopian focus, namely the digital peer-to-peer details of “blurring the lines between the personal and the professional”. Sundararajan’s boosterish analysis of this “intriguing mix of ‘gift’ and ‘market’” urges “new generalists” to get some of that rentier action – via your flat, or perhaps some lowest-bidder floor-scrubbing. The other term that crops up in such discussions is “gig economy”. If you’re not sure why that sounds an ominous note, ask a musician.
The Storyteller: Tales Out of Loneliness
Walter Benjamin
Verso
Named for his 1936 essay on Nikolai Leskov, this “first major collection of short stories” from that most literary and magpie of philosophers is both more and less straightforward than billed. A curate’s egg, inevitably; a jumbled, Hoffmanesque Wunderkammer of dreams, riddles, novella fragments, children’s rhymes, traveller’s yarns, a stalkerish Still Story and Four Tales’ gnomic folkery. Benjaminites, schooled in sifting, will be as beguiled by the textual orts and oddments as by Nordic Sea’s incantatory opening: “‘The time in which even he who has no home lives’ becomes, for the traveller who left none behind, a palace.”
From Notes to Narrative: Writing Ethnographies that Everyone Can Read
Kristen Ghodsee
University of Chicago Press
This slim, jam-packed, how-to book by a gender scholar and author of several fine studies of post-communism Europe is, she says in a position-staking introduction, “Why Write Clearly?”, “the book I wish I had as a graduate student trying to figure out how to write my dissertation and as a junior scholar struggling to transform that dissertation into a book”. The chapter headings tell the tale, and sell it splendidly: choose a subject you love; put yourself into the data; integrate your theory; embrace dialogue; minimise scientism; unclutter your prose; revise!
The Naked Blogger of Cairo: Creative Insurgency in the Arab World
Marwan M. Kraidy
Harvard University Press
A US-based media scholar argues that the human body, not Twitter or texts, was the key medium of political expression in the Arab Uprisings, from fruit vendor Tarek al-Tayeb Mohamed Al-Bouazizi’s self-immolation to the titular blogger Aliaa al-Mahdi, an American University in Cairo student later granted political asylum in Sweden. Kraidy’s study takes in the digital body politic and street murals; Morsi and Sisi; “virginity examination” rape-by-police; the rap of El Général and the protests of Baguette Man and Captain Bread; Quahera comics and Syrian web satire Top Goon and “the creative-curatorial-corporate complex”.
Podemos: In the Name of the People
Íñigo Errejón in Conversation with Chantal Mouffe
Lawrence & Wishart
In a book whose publication came at the urging of the late geographer Doreen Massey, the past, present and future of the Left are chewed over by a University of Westminster political theorist and the persuasively low-key political secretary of Spain’s burgeoning anti-austerity party, Podemos (“We can”). We get Gramsci and Greece, Latin America and Le Pen, populism and Spain’s transition to democracy, and although Marxism’s greatest hits play on (“struggle for hegemony”, “false consciousness”), the conversation (in Sirio Canós Donnay’s limpid translation) is thoughtful, not theory-strangled. Owen Jones’ foreword, whistle-stopping through Sanders-Blair-Trump-E.P. Thompson-Corbyn for context, is an upbeat scene-setter.
Register to continue
Why register?
- Registration is free and only takes a moment
- Once registered, you can read 3 articles a month
- Sign up for our newsletter
Subscribe
Or subscribe for unlimited access to:
- Unlimited access to news, views, insights & reviews
- Digital editions
- Digital access to THE’s university and college rankings analysis
Already registered or a current subscriber?